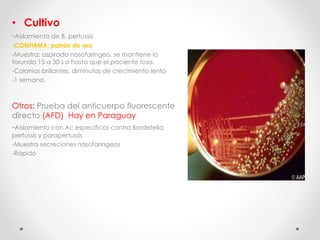
• Cultivo
-Aislamiento de B. pertussis
-CONFIRMA; patrón de oro
-Muestra: aspirado nasofaríngeo, se mantiene la
torunda 15 a 30 s o hasta que el paciente tosa.
-Colonias brillantes, diminutas de crecimiento lento
-1 semana.
Otros: Prueba del anticuerpo fluorescente
directo (AFD) Hay en Paraguay
-Aislamiento con Ac especificos contra Bordetella
pertussis y parapertussis
-Muestra secreciones nasofaringeas
-Rápido

La tos ferina o coqueluche es una infección aguda de las vías respiratorias causada principalmente por la bacteria Bordetella pertussis. Se caracteriza por tos intensa en paroxismos, que puede durar varias semanas. Su diagnóstico se basa en los síntomas clínicos y puede confirmarse con pruebas de laboratorio. El tratamiento incluye antibióticos y la prevención se logra mediante la vacunación con la vacuna pentavalente DPT.